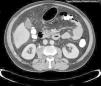

Precisar las características clínicas de los pacientes con absceso del músculo psoas (AP) y las posibles diferencias existentes entre los AP piógenos o tuberculosos.
Pacientes y métodosRevisión retrospectiva de los pacientes diagnosticados de AP en un hospital (1983-2009). Se establecieron dos grupos, piógenos y tuberculosos, y se compararon sus hallazgos clínicos, analíticos y evolución.
ResultadosSe incluyeron 30 pacientes con AP, 25 piógenos y 5 tuberculosos, En 9 ocasiones fueron primarios y en 21 secundarios (a patología esquelética en 8 a patología urológica en 8 y a gastrointestinal en 8). No se observaron diferencias clínicas entre ambos grupos. Los pacientes con AP piógenos tendieron a tener mayores cifras de leucocitos (13.871 vs. 8.560/mm3, p=0,018) y de velocidad de sedimentación globular (VSG) (108 vs. 17mm/h, p<0,0001) y menores de hemoglobina (11 vs. 14g/dL, p=0,008) Se diagnosticaron por tomografía computarizada (TC) en 29 pacientes y por resonancia magnética en 1, ambas con una sensibilidad diagnóstica del 100%, frente al 50% de la ecografía. La lateralidad izquierda fue menos frecuente en los AP piógenos (44 vs. 100%, p=0,031). Los hemocultivos y el cultivo de pus del absceso fueron positivos en el 22% y 82% de las ocasiones en las que se realizó. Los gérmenes aislados con más frecuencia fueron bacilos gramnegativos, Streptococcus spp. y S. aureus. El 50% de los casos fueron drenados percutáneamente, el 13% quirúrgicamente y el 3% por ambas técnicas. Fallecieron 2 pacientes, ambos con absceso piógeno.
ConclusionesLos abscesos piógenos secundarios constituyen el grupo de AP más frecuente. La TC es el procedimiento diagnóstico de elección. La presencia de leucocitosis, anemia, VSG elevada y la lateralidad derecha sugieren etiología piógena. El drenaje percutáneo está sustituyendo al quirúrgico y permite obtener muestras diagnósticas.
To describe the clinical characteristics of patients with abscess on the psoas muscle (PA) and to identify the possible differences existing between pyogenic and tuberculous etiologies.
Patients and methodsA retrospective review of patients diagnosed of PA in one hospital was conducted (1983-2009). Two groups were established, that is pyogenic and tuberculous, and the clinical findings, analyses and evolution were compared.
ResultsThirty PA were included, 83% pyogenic and 17% tuberculous, average age 53 years. On 9 occasions, 30% were primary and on 21 occasions, 70% secondary (to skeletal pathology in 8, to urological in 8 and to gastrointestinal in 8). No clinical differences were observed between both groups. Pyogenic and tuberculous etiologies were differentiated analytically through leukocyte values (13,871 vs. 8,560/mm3, p=0.018), hemoglobin (11 vs. 14g/dL, p=0.008) and erythrocyte sedimentation rate (ESR) (108 vs. 17mm/h, p<0.0001). Abscesses were diagnosed by computed tomography (CT) in 29 patients (97%) and by magnetic resonance in 1 (3%), both with a diagnostic sensitivity of 100%, as opposed to 50% for ultrasound scanning. Left laterality was less frequent in pyogenic abscesses (44% vs. 100%, p=0.031). The blood cultures were positive in 22% and abscess pus culture in 82%. Gram negative bacilli, Streptococcus spp. and S. aureus were the most frequent isolations. A total of 67% were drained: transcutaneously 50%, surgically 13% and both techniques 3%. Two patients died (7%), both with pyogenic abscess.
ConclusionsSecondary pyogenic abscesses constitute the most frequent PA group. CT is the diagnostic procedure of choice. Leukocytosis, anemia, raised ESR and right laterality suggest pyogenic etiology. Transcutaneous drainage is substituting surgical drainage and also makes it possible to obtain diagnostic samples.
Artículo
Diríjase desde aquí a la web de la >>>FESEMI<<< e inicie sesión mediante el formulario que se encuentra en la barra superior, pulsando sobre el candado.

Una vez autentificado, en la misma web de FESEMI, en el menú superior, elija la opción deseada.

>>>FESEMI<<<